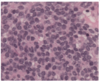
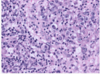

Balint syndrome lesion location
bilateral parieto-occipital lobes
Balint Syndrome characterized by
optic ataxia, ocular apraxia, and simultagnosia
optic ataxia
deficit of reaching objects under visual guidance
ocular apraxia
inability to voluntarily move the eyes when oculomotor function is in tact
simultagnosia
inability to visually perceive more than 1 object at a time
prosopagnosia lesion location
bilateral fusiform gyri
Anton syndrome localization
bilateral medial occipital lobes
Anton syndrome characterized by
visual anosognosia characterized by cortical blindness, denial of such blindness, and confabulation
myoclonus-dystonia genetics
autosomal dominant movement disorder associated with epsilon-sarcoglycan (SGCE) or DYT11 gene on chromosome 7q21
myoclonus-dystonia characterized by
brief involuntary jerks mainly affecting necks, arm, and trunk as well as sustained twisting resulting from abnormal postures usually of the neck and/or hand.
begins in adolescence.
assoc with psych conditions.
alcohol improves
central cord syndrome caused by
low-velocity, low-impact trauma in setting of pre-existing spondylotic disease
MRI findings in corticobasal degeneration
midcallosal atrophy and asymmetric atrophy of the parieto-frontal cortex
corticobasal degeneration histology
neocortical ballooned neurons, referred as achromatic neurons, and astrocytic plaques containing tau
corticobasal degeneration characterized by
histologic findings of tauopathy.
strongly asymmetric limb rigidity/hemi-dystonia, akinesia or myoclonus, alien limb phenomenon, apraxia, and cortical sensory loss.
early gait instability and cognitive decline
neurodegenerative conditions associated with REM sleep behavior disorder
parkinson disease, multiple system atrophy (MSA), and lewy body disease (LBD)
neurodegenerative condition associated with ALS
FTD has an autosomal dominant inheritance pattern in up to 20% of cases and can be associated with ALS in up to 15% of patients
Path: ubiquitin or tau inclusions. Pick cells described, which are tau protein deposits within neurons
Pick cells
tau protein deposits within neurons, can be seen in FTD
AD pathology
extracellular deposition of amyloid and intracellulary neurofibrillary tangle depositions.
alpha-synuclein deposition in cortical layers V and VI
LBD.
MRI in neurosarcoidosis
patchy and thick leptomeningeal enhancement, hypothalamic and pituitary involvement, and other less specific white matter lesions
lateral medullary syndrome
ipsilateral horner syndrome, sensory loss of ipsilateral hemiface, dysarthria and dysphagia, ipsilateral ataxia.
third order neuron lesion of the oculosympathetic pathway
partial Horner with mi0osis, anisocoria more apparent in dim light (impaired sympathetic response) and ptosis. contralateral hemineglect can also be a feature
first order sympathetic neurons
arise from posterolateral hypothalamus
what can confirm Horner syndrome
cocaine and apraclonidine